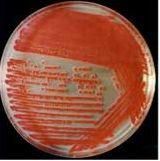
粘質沙雷氏菌 粘質沙雷氏菌

基本內容
編號 : 050502029 生防菌名稱 : 粘質沙雷氏菌 生防菌拉丁學名 : Serratia marcescens 生防菌類別 : 細菌 形態特徵 : 菌株的菌落基本上是凸起,中心不透明,邊緣不規則,大小為1~2.5 mm,均產生紅色色素(圖版Ⅰ-3)。.在營養瓊脂平板上可產生樹枝狀向左鏇的特別菌落(圖版Ⅰ-1);在特殊條件下培養時可出現由小逐漸變大、連續有序排列的雙列菌落(圖版Ⅰ-2)。菌體為革蘭氏陰性短桿菌,大小為(1~1.3)μm×(0.7~1.0)μm,周生鞭毛,有動力,無莢膜,無芽孢。 生理生化特徵 : 28℃下培養產生紅色色素,37℃下培養不產紅色色素而恢復在28℃下培養又產生紅色色素;革蘭氏陰性,周生鞭毛;從耐紫外線照射試驗中發現菌株中具有抗紫外線的物質存在;左鏇狀菌落和雙列菌落如何形成尚未清楚。 防治對象 : 黃脛小車蝗 生防特點 : 以黃脛小車蝗成蟲為供試蟲對HBZBS-1菌株進行了室內毒力測定。結果表明,該菌株對黃脛小車蝗有很高的殺蟲毒力。HBZBS-1菌株培養原液對黃脛小車蝗成蟲有很好的殺蟲效果,感染4d後的死亡率達87%。室內重複試驗結果表明,該菌株對黃脛小車蝗成蟲的殺蟲效果穩定。將培養液稀釋10倍後,對黃脛小車蝗的殺蟲效果已明顯降低,這說明初始感染量是影響其殺蟲效果的重要因子。含少量活菌體的上清液的殺蟲效果明顯高於不含活菌體的上清液的殺蟲效果;純活菌體菌液對黃脛小車蝗成蟲的防治效果為83%,與培養母液的殺蟲效果基本相當,明顯高於其他處理液的防治效果。由此可見,對黃脛小車蝗起主要殺蟲作用的是活菌體,純菌體代謝產物也表現出一定的殺蟲毒力,但殺蟲活性較低。經100℃水浴處理的含少量菌體的上清液對黃脛小車蝗成蟲無殺蟲活性,但經紫外線處理的含少量菌體的上清液仍具有一定的殺蟲活性。說明HBZBS-1菌株及具有殺蟲活性的代謝產物經一定強度的紫外線照射而不至喪失活性,但耐熱性較差。 粘質沙雷氏菌 又稱靈桿菌,為細菌中最小者,約0.5×(0.5~1.0)微米。周身鞭毛,能運動。無莢膜,無芽胞,在普通瓊脂平板上25~30℃培養1~2天出現粘性、中心顆粒狀、有惡臭的菌落。約半數菌株能產生紅色的靈菌素(prodigiosin)。在室溫條件下易促進色素的生成,因本菌小且有色素,常用於檢定濾菌器的質量。有46個血清型,血清型與色素產生無關。一般不致病,近年有報告說可引起肺部感染、腦膜炎、心內膜炎、尿路感染、灼傷後敗血症等。尤其在類固醇類激素,免疫抑制藥造成機體免疫力降低時,容易發病。
代謝產物
靈菌紅素(Prodigiosin,正式名稱為2-methyl-3-pentyl-6-methoxyprodiginine)是Prodiginin(中文名不詳)的一種。它具有Prodiginin的基本結構,也就是三吡咯環,其中的一個吡咯環C2上帶有一個甲基,C3上則有一個戊基。靈菌紅素是一種紅色物質,可由粘質沙雷氏菌(Serratia marcescens)等細菌合成的次級代謝產物。雖然其對於生產者的作用和意義還不是徹底明了,但它已被發現具有多種生物活性作用,能抗癌,抗微生物,抗瘧疾,抗霉,免疫抑制的作用。其中抗癌方面,因為其具有癌組織的高針對性和對正常細胞則表現的低毒害作用,而成為一種非常有潛力的抗癌物質
臨床標本中粘質沙雷氏菌的鑑定及藥敏分析
[摘要] 粘質沙雷氏菌廣泛分布於自然界,近年來漸成為臨床上常見的條件致病菌。本文報導了46株從臨床標本中分離得到的粘質沙雷氏菌的生化特性。本菌屬於腸桿菌科,IMViC試驗42株為--++模式(91.3%),4株為-+++模式(8.7%)。主要生化試驗氧化酶陰性,葡萄糖發酵,硝酸鹽還原陽性,葡萄酸鹽陽性,苯丙氨酸陰性,動力陽性,山梨醇陽性,DNA酶陽性。與同屬中其他種的主要區別是阿拉伯糖、棉子糖、木糖均為陰性。對46株粘質沙雷氏菌進行14種抗生素的藥物敏感試驗,結果表明粘質沙雷氏菌對多種抗生素均表現出較高的耐藥率。
[關鍵字] 粘質沙雷氏菌;藥物敏感;生化實驗
粘質沙雷氏菌廣泛分布於自然界,是水和土壤中的常居菌群,亦是臨床上常見的條件致病菌,在機體免疫功能降低時可引起肺部和尿道感染以及敗血症。我們對從臨床標本中分離出的46株粘質沙雷氏菌進行了鑑定和藥物敏感試驗,結果報告如下。
1材料和方法
1.1材料
1.1.1菌株來源46株粘質沙雷氏菌均分離自本院臨床標本,其中尿液16株,前列腺液7株,胸腹水6株,咽喉分泌物6株,血液4株,傷口分泌物4株,膽汁3株。
1.1.2培養基用法國產哥倫比亞瓊脂及馬頭羊血製備。生化鑑定用法國生物梅里埃公司生產的API 20E鑑定條。抗生素紙片由北京天壇藥物生物技術開發公司生產。微量生化反應管由浙江省軍區防疫檢疫所生產。
1.2方法
1.2.1細菌分離鑑定細菌分離培養按常規方法進行,標本接種血瓊脂和麥康凱平板,35 ℃培養18 h~24 h,凡氧化酶陰性的革蘭陰性桿菌,採用API 20E鑑定。用微量生化反應管進行補充生化試驗。主要是葡萄酸鹽、苯丙氨酸、動力、山梨醇、DNA酶、阿拉伯糖、棉子糖、木糖以及葡萄糖OF試驗。
1.2.2藥物敏感試驗採用KB法,對46株粘質沙雷氏菌進行14種常用抗生素的敏感性測定,並以大腸埃希菌ATCC 25922進行藥物敏感試驗質量控制,所有質控結果均符合國際臨床實驗室標準委員會(NCCLS)藥敏質控標準。
2結果
2.1菌株鑑定血瓊脂平板上形成大圓形、灰白色、凸起、濕潤、邊緣整齊、不溶血菌落。麥康凱平板上形成無色半透明菌落。革蘭染色為陰性小桿菌。生化試驗氧化酶陰性,葡萄糖發酵,硝酸鹽還原陽性者初步可推斷為腸桿菌科細菌;葡萄酸鹽陽性,苯丙氨酸陰性,動力陽性,山梨醇陽性,DNA酶陽性者可推斷為沙雷氏菌屬。進一步生化結果如表1者可鑑定為粘質沙雷氏菌。IMViC試驗42株為--++模式(91.3%),4株為-+++模式(8.7%)。
2.246株粘質沙雷氏菌對14種常用抗生素的耐藥性測定結果見表2。
表146株粘質沙雷氏菌生物學特性(略)
表246株粘質沙雷氏菌對14種常用抗生素的耐藥率(略)
3討論
粘質沙雷氏菌長期被認為是水和土壤中的常居菌群,對人體無害,只是近年來才發現其可致人體感染,包括泌尿道、呼吸道、腦膜和傷口感染,可引起菌血症、內毒素休克和心內膜炎。近年來由粘質沙雷氏菌所致的院內感染,尤其是引起傷口感染有上升趨勢,有引起心臟外科、兒科病房爆發流行的報導。應引起臨床醫務人員的高度重視。沙雷氏菌屬其他種雖亦偶爾分離,但是否為病原菌尚末確定。沙雷氏菌的一個特點是產明膠酶、脂酶和DNA酶,其與克雷伯氏菌屬、腸桿菌屬、哈夫尼亞菌屬的主要區別是DNA酶陽性。沙雷氏菌屬包括9個種,臨床上最常見,也是生化特徵最明顯的是粘質沙雷氏菌,粘質沙雷氏菌與同屬中其他種的主要區別是阿拉伯糖陰性,棉子糖陰性,木糖陰性。從土壤或水中分離到的粘質沙雷氏菌在有氧,特別是在20 ℃培養時會產生一種不擴散的紅色色素靈菌紅素,但臨床分離菌株大部分不產色素。粘質沙雷氏菌生物型的鑑定:可利用其O和H抗原加以鑑定,但抗血清不易獲得。替代方法包括碳利用試驗和其他表型鑑定方法,此類方法已在流行病學調查中與血清型法聯合套用。其它產紅色色素的種包括紅色沙雷氏菌和普城沙雷氏菌,但較少從人體分離到。臭味沙雷氏菌可從痰、血和腦脊液標本中分離到,可產生特徵性的腐臭馬鈴薯味,有助於鑑別。居泉沙雷氏菌從臨床標本中也可分離出,主要見於傷口滲出液,但居泉沙雷氏菌的生化反應(VP、明膠酶、脂酶、DNA酶陰性)不典型,將來有可能進行進一步分類[1,2]。我們檢測到的46株粘質沙雷氏菌對14種常用抗生素的耐藥率均在39.1%以上,其中對紅黴素、四環素、環丙沙星、慶大黴素、哌拉西林、複方新諾明、頭孢噻吩的耐藥率均在50%以上,顯示沙雷氏菌通常對多種抗生素耐藥。粘質沙雷氏菌的不產色素生物型常和多種抗藥R質粒介導的耐藥因子有關[3]。
參考文獻:
[1]J.Gerald Collee,Andrew G.Fraser,Barrie P.Marmion,et al.Practical Medical Microbiology[J].churchill livingstone,1996:371.
[2]Farmer J J Ⅲ,Davis B R,HickmanBrenner F W,et al.Biochemical identification of new species and biogroups of Enterbacteriaceae isolated from clinical specimens[J].Journal of Clinical Microbiology,1985,21:4676.
[3]葉應嫵,李健齋,王玉琛.臨床實驗診斷學(下)[M].人民衛生出版社,1989:20632064.
生化反應
粘質沙雷氏菌(Serratia marcescens)
| 性狀 | 結果 | 性狀 | 結果 | 性狀 | 結果 |
| 革蘭氏染色 ,(24h) | - | 氧化酶(24h) | - | 吲哚 | - |
| 甲基紅 | [-] | V-P | + | 檸檬酸鹽(Simmons) | + |
| 硫化氫 | - | 脲酶 , 水解 | [-] | 苯丙氨酸脫氨酶(24h) | - |
| 賴氨酸 , 脫羧 ,酸 | + | 精氨酸 , 雙水解 ,酶 | - | 鳥酸氨脫羧酶 | + |
| 運動性 | + | 明膠液化 ,(22℃) | + | KCN生長 | + |
| 丙二酸 , 利用 | - | 葡萄糖產酸 | + | 葡萄糖產氣 | d |
| D-, 阿東 ,醇產酸 | d | D-拉伯糖產酸 | - | 纖維二糖產酸 | - |
| 衛矛醇 ,產酸 | - | 甘油產酸 | + | 間-肌醇產酸 | [+] |
| 乳糖產酸 | - | 麥芽糖 ,產酸 | + | D-, 甘露醇 ,產酸 | + |
| D-甘露糖產酸 | + | 蜜二糖產酸 | - | α-甲基-D-葡萄, 糖苷 ,產酸 | - |
| 棉子糖產酸 | - | L-鼠李糖產酸 | - | 柳醇產酸 | + |
| D-山梨醇產酸 | + | 蔗糖產酸 | + | 海藻糖產酸 | + |
| D-木糖產酸 | - | 粘液酸 ,鹽產酸 | - | 酒石酸 ,鹽(Jordans)產酸 | [+] |
| 七, 葉靈 , 水解 | + | 乙酸鹽利用 | d | 硝酸鹽還原 | + |
| DNase(25℃) | + | 脂酶 | + | ONPG | + |
| 色素 | dR | 鞭毛排列 | p | 接觸酶產生(24h) | + |
| 氧化-發酵 | F |